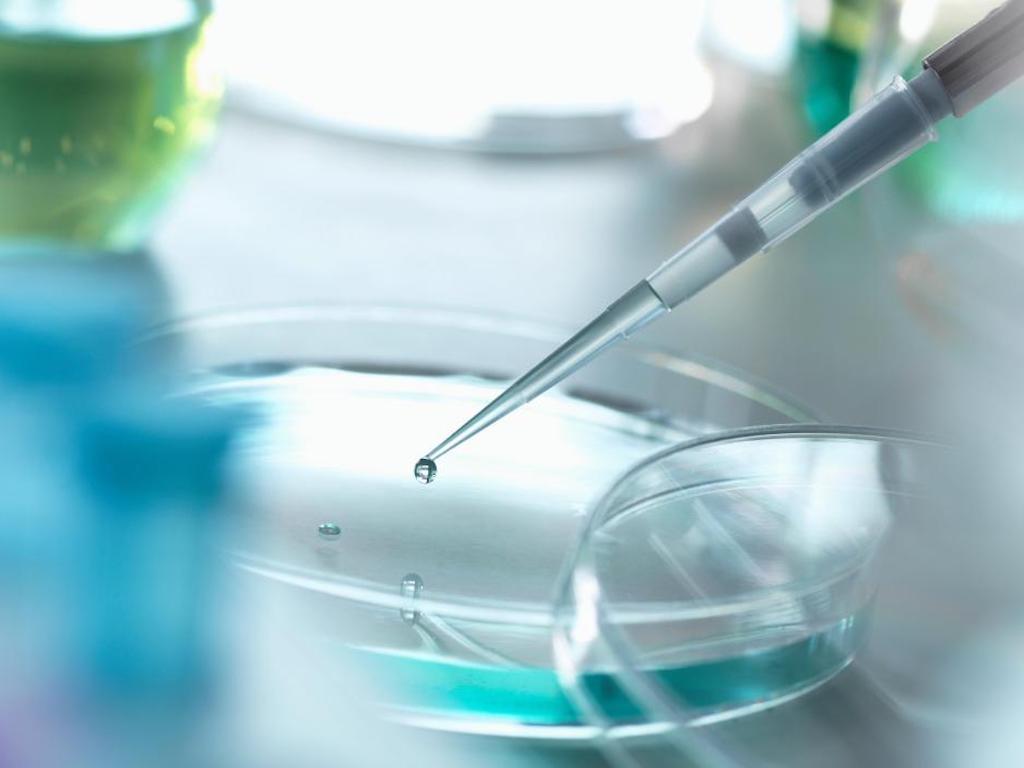

Exclusive: Seoul Startup DaNAgreen’s Affordable 3D Scaffolds Enables Large-Scale Cultured Meat Production
Seoul-based startup DaNAgreen, who originally developed its proprietary scaffold that helps cells grow into a 3D structure for biomedical applications, is now making cultured meat its mission. Adapting its initial scaffolding dubbed Protinet for cell-based meat production, the startup says it can now be produced “at a price a thousand times cheaper than the original”, which can enable significant scaling-up of cultured meat production. Beyond scaffolds, DaNAgreen has also set its sights on developing a line of cells, culture media and a cultivated meat bioreactor too.
Co-founded in 2017 by Kiwoo Kim, Jenna Ju and Jay Jee, DaNAgreen first set out to create its patented Protinet scaffold product that enables cells to attach and grow around a 3D structure for clinical applications. But last year, the company decided to take its technology and evolve into a cultured meat firm, to help accelerate the development of sustainable, crisis-resilient and ethical proteins.
Protinet, the company’s scaffold, is made from a plant-derived protein mass and contains lots of pores where cells can live and grow. One problem was that the protein that DaNAgreen was using was expensive, so the team began to test different formulas of plant-based protein isolate and have finally come up with a cost-efficient mix that they claim is the cheapest of all available scaffold and microcarrier materials on the market.
The price will drop further when the production scale becomes bigger.
DaNAgreen
Speaking to Green Queen, DaNAgreen said that to produce one kilogram of cultivated meat requires around 23,000 of their scaffolds – which costs just US$11.50. “And the price will drop further when the production scale becomes bigger,” the startup said.

While the cultivated protein industry is on a high following the landmark sale of Eat Just’s cultured chicken in Singapore after it gained the world’s first regulatory approval from authorities in December 2020, affordable scaffold material still remains a huge barrier for food techs to make their product cheap enough to go to market.
In addition, many startups are still using gelatin-based fibres to develop cultured meat, posing an issue to ensure the product is 100% cruelty-free and suitable for vegans – though there is growing innovation within this sector. Ohio’s Matrix Meats, for instance, has created a nanofibre scaffold, while Perth-based Cass Materials is creating its biodegradable scaffolds out of nata de coco.
Selling Protinet scaffolds to other cultivated meat companies is an easy option, but DaNAgreen aims to go further than that.
DaNAgreen

Joining the competition is Tiamat Sciences in Brussels, who is using plant-based molecular farming technology to create a number of recombinant protein ingredients – enzymes, antibodies, scaffolding and growth factors at a fraction of the price compared to their competitors.
DaNAgreen says that like Tiamat Sciences, its goal isn’t just to produce scaffolds. Instead, it is committed to developing “all four main components of cultivated meat”, from cells to the culture media and even bioreactors.
“Selling Protinet scaffolds to other cultivated meat companies is an easy option, but DaNAgreen aims to go further than that,” the startup told Green Queen, adding that its commercialisation timeline is set for the next two to three years.
Among some of the specific projects the company already has underway is creating an animal-free replacement for fetal bovine serum (FBS), which is often used as culture media, and an entire bioreactor system that is “optimised for mass production of cultivated meat”.
All images courtesy of DaNAgreen.